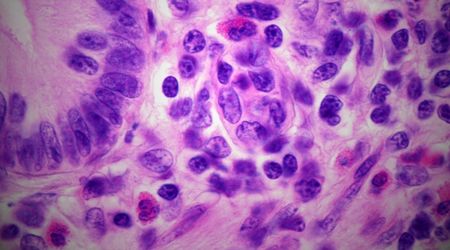

Eozinofilik gastroenterit nedir? Eozinofilik gastroenterit neden olur? Eozinofilik gastroenteri tedavisi
Eozinofilik gastroenterit, mide ve bağırsak duvarında eozinofil adı verilen bağışıklık hücrelerinin anormal şekilde birikmesiyle ortaya çıkan bir hastalıktır. Bireylerde nadiren görülen bir sindirim hastalığıdır.
Eozinofilik Gastroenterit Nedir?
Eozinofilik gastroenterit, eozinofil adı verilen beyaz kan hücrelerinin mide ve bağırsak duvarında anormal şekilde birikimi ile bir sindirim sistemi hastalığıdır. Bu hastalık nadir olarak görülmektedir. Bu hastalık genelde bağışıklık sistemiyle ilişkili olup, alerjik mekanizmalarla bağdaştırılır. Mide, ince bağırsak ve nadiren kalın bağırsağın farklı katmanlarını içerebilir.
Eozinofilik Gastroenterit Belirtileri
Eozinofilik gastroenternit, tutuluma uğrayan gastrointestinal bölgeye değişkenlik gösterir. Bu hastalığın en yaygın semptomları şu şekilde sıralanabilir:
- Karın ağrısı ve kramp
- Bulantı ve kusma
- İshal veya kabızlık
- Şişkinlik ve gaz
- Kilo kaybı
- Yemek sonrası erken doyma
- Kansızlık
- Protein kaybına bağlı ödem

Eozinofilik Gastroenteritin Nedenleri ve Risk Farktörleri
1. Besin Alerjileri
Hastalıkla ilgili en sık karşılaşılan nedenlerin başında gıda alerjileri gelir. Özelllikle süt, yumurta, soya, buğday, fındık, balık ve deniz ürünleri gibi alerjenler, eozinofilik inflamasyona yol açabilir. Bazı hastalarda tek bir besin tetikleyici olurken, bazılarında çoklu gıda duyarlılığı görülebilir.
2. Alerjik Hastalık Öyküsü
Atopi, yani alerjik hastalıklara yatkınlık, eozinofilik gastroenterit hastalığıyla yakından ilgilidir. Şunlar risk faktörü olarak kabul edilir.
- Alerjik rinit
- Astım
- Atopik dermatit
- Gıda alerjileri
3. Genetik Yatkınlık
Bahsedilen alerjik rahatsızlıklar aile bireylerinde de varsa, genetik bir yatkınlık sonucuna ulaşılabilir. Eozinofilik gastroenterit, bazı bireylerde kalıtsal bağışıklık sisteminin aşırı duyarlılığına bağlı olarak ortaya çıkabilir.
4. Bağışıklık Sistemi Bozuklukları
Bağışıklık sisteminde dengesizlik veya aşırı duyarlılık, vücutta eozinofil üretiminin artmasına ve bu hücrelerin sindirim sistemine göçüne neden olabilir. Bu durum da mide ve bağırsak duvarlarında inflamasyona yol açar.
5. Çevresel Faktörler
Bazı kimyasallara maruz kalmak, sigara dumanının olduğu yerde bulunmak, endüstriyel toksinler gibi çevresel etkenlerin de bağışıklık sistemi üzerinde etkileri vardır. Bu da eozinofilik gastroenterit hastalığına davetiye çıkarabilir.
Eozinofilik Gastroenterit Tanısı Nasıl Konur?
Eozinofilik gastroenterit hastalığının teşhis süreci için özenli ve dikkatli bir değerlendirme gerekir. Genellikle aşağıdaki şekillerde tanı konur:
- Laboratuvar testleri: Kan testlerinde eozinofili saptanabilir.
- Endoskopi ve biyopsi: Sindirim sistemi mukozasından alınan doku örneklerinde eozinofil infiltrasyonu gösterilir.
- Görüntüleme yöntemleri: Batın ultrasonu, bilgisayarlı tomografi veya manyetik rezonans görüntüleme gibi yöntemlerle bağırsak duvar kalınlaşması değerlendirebilir.
- Dışkı incelemesi: Parazit veya enfeksiyon dışlanmalıdır.
- Besin eliminasyon testleri: Gıda alerjileri araştırılır.
Eozinofilik Gastroenterit Tedavisi
Eozinofilik gastroenteritin hastalığında tedavi yaklaşımı, hastalığın şiddetine ve tutulum bölgesine göre değişkenlik gösterir. Klasik tıpta eozinofilik gastroenterinitin tedavi yöntemleri arasında, diyet tedavisi, kortikosteroidler, antihistaminikler ve löktrien antagonistler ve immünomodülatörler yer alır.
Eozinofilik Gastroenterite Bütüncül Tedavi Yaklaşımı
Eozinofilik gastroenterite bütüncül tıp yaklaşımının faydaları vardır. Bütüncül tıpta hastanın genel iyilik halinin artımını amaçlanır. Bütüncül yaklaşıma göre bu hastalığa iyi gelebilecek durumlar şu şekilde sıralanabilir:
- Anti-inflamatuar beslenme: İşlenmiş gıdalardan uzak, bağışıklık sistemini destekleyen besinlerle zenginleştirilmiş diyet önerilir.
- Bağırsak mikrobiyotasının düzenlenmesi: Probiyotik ve prebiyotik takviyelerle gastrointestinal flora desteklenebilir.
- Stres yönetimi: Kronik stres bağışıklık sistemini etkileyebileceği için yoga, meditasyon gibi yöntemler iyi gelebilir.
- Fitoterapi ve destekleyici tedaviler: Bilimsel temelli bitkisel destek ürünleri, doktor kontrolünde kullanılabilir.
- Biorezonans
- Hacamat
- Ozon Tedavisi
Eozinofilik Gastroenterit Hakkında Sık Sorulan Sorular
Eozinofilik gastrit ile eozinofilik gastroenterit arasındaki fark nedir?
Her iki hastalıkta da eozinofillerin gastrointestinal dokuda birikimi söz konusudur. Ancak:
- Eozinofilik gastrit yalnızca mide dokusunda eozinofil infiltrasyonu ile sınırlıdır.
- Eozinofilik gastroenterit mide, ince bağırsak ve bazen kalın bağırsağı da içerecek şekilde daha yaygın bir tutulum gösterir.
Bu farklar tedavi planlaması açısından önemlidir.
Eozinofilik Gastroenterit Kalıcı Mıdır?
Hastalık kronik seyir gösterebilir ancak, uygun tedavi ile kontrol altına alınabilir.
Eozinofilik gastroenterit çocuklarda görülür mü?
Evet görülür. Özellikle besin alerjilerine bağlı olarak çocuklarda da sık ratlanır.
Eozinofilik gastroenterit başka hastalıklarla karışabilir mi?
Crohn hastalığı, çölyak hastalığı veya paraziter enfeksiyonlarla benzer semptomlar gösterebilir.
Eozinofilik Gastroenteritin Tedavisi Sırasında Nelere Dikkat Edilmeli?
Beslenme düzeni, ilaç kullanımı ve tamamlayıcı tıp uzmanı tarafından düzenli takibi önem taşır.
Eozinofilik gastroenterit hastalığı için bütüncül yaklaşım protokolleri ile ilgili daha fazla bilgi almak ve ücretsiz ön görüşme için iletişime geçebilirsiniz.